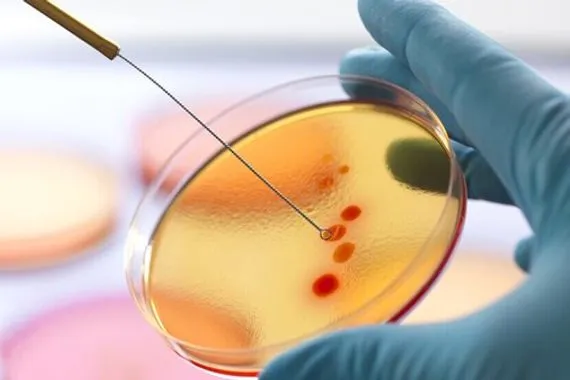
ابتكار مضاد حيوي لعلاج العدوى المقاومة

ابتكار مضاد حيوي لعلاج العدوى المقاومة
ابتكر علماء معهد فيزياء الكيمياء الحيوية والجامعة التقنية الروسية مضادا حيويا جديدا على شكل دقائق نانوية مكوناته النشطة الأحماض الدهنية للطحالب المترابطة.
[["p","وتقول ماريا سوكول الباحثة في معهد فيزياء الكيمياء الحيوية التابع لأكاديمية العلوم الروسية، في حديث لصحيفة \"إزفيستيا\": \"هذا الدواء المركب هو مضاد حيوي واسع الطيف: وفقا لذلك، يمكن لبعض المركبات أن تؤثر ليس فقط على البكتيريا، ولكن أيضا على مسببات أمراض الفطريات الشبيهة بالخميرة\"."],["p","ويساعد الدواء المبتكر في علاج المكورات العنقودية الذهبية وأنواع مختلفة من التسمم وداء الرشاشيات وداء المبيضات وأمراض أخرى."],["p","وتقول يلينا نيكولسكايا كبيرة الباحثين في المعهد: \"لقد أظهرت الاختبارات الأولية فعالية وسلامة الدواء المبتكر. المرحلة التالية هي اختباره على الحيوانات. أي أن إجراء دورة كاملة من الاختبارات ما قبل السريرية (على الحيوانات) يستغرق حوالي ثلاث سنوات. وإذا حصلنا على نتائج إيجابية، فيمكننا الانتقال إلى الاختبارات السريرية على البشر\".انتهى / 25م"]]





















